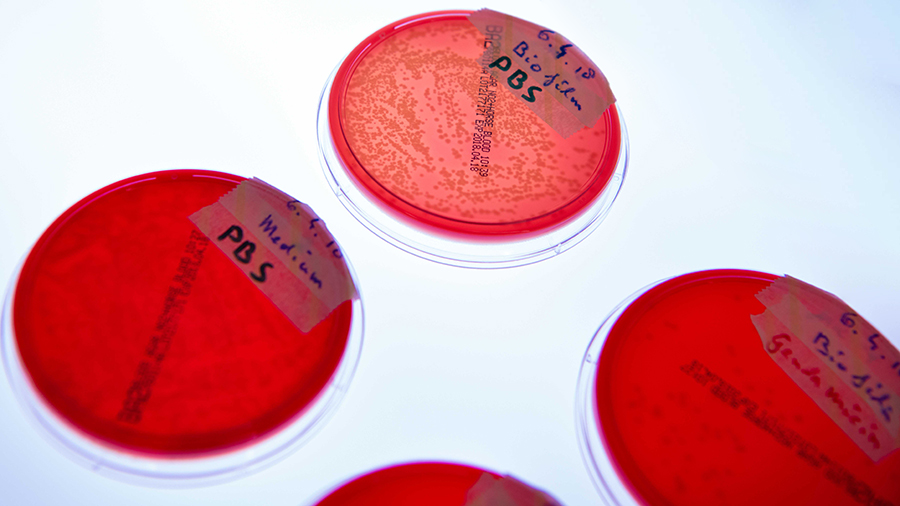

Research
In its work to further the AO mission, the AO Research Institute Davos (ARI) advances orthopedic patient care through innovative research and development.
Extraordinary achievements
Against the backdrop of the COVID-19 pandemic, ARI contributed significantly to an extraordinary 2020 for the AO, with a new record high of 116 publications (compared to around 70 in a typical year). At the same time, its publications’ average impact factor increased to 4.5, compared to 3.5–3.6 in a normal year, and the institute received CHF 3.2 million in extramural funding in 2020.
In parallel, the institute licensed its groundbreaking tissue engineering technology, Sound-Wave Induced Morphogenesis (3D SIM), to the newly created mimiX biotherapeutics from Switzerland. SIM is a gentle, fast, and easy method used to generate multi-cellular, spatially orchestrated tissue constructs using sound waves. It has excellent potential for use in operation rooms in the future due to its speed, and as no needles are involved in the printing process, there is no fluid stress on the cells printed and consequently no cell damage or death.
Further proof of ARI’s groundbreaking work was a study published in eCM Journal, showing that ARI’s thermoresponsive, bioresorbable hydrogel—used in combination with systemic antibiotics—cleared MRSA in 100 percent of sheep studied, compared to 50 percent with conventional IV therapy and cement releasing antibiotics. Moreover, ARI in 2020 underscored its innovation legacy with the launch of OSapp, an interactive, virtual osteosynthesis software tool and learning platform. The app is aimed at surgeons, helping them understand the biomechanical concepts underlying the principles of fracture fixation.
Honoring a research pioneer
Seventeen papers of 64 submitted were accepted for publication in a special “In Tribute” edition of Injury, honoring the late Prof Stephan M Perren, an AO founding father and senior scientific advisor. The special edition was published in January 2021. Perren, who was globally renowned for his strain theory explaining tissue deformation as a critical mechanical factor that controls bone healing, died on November 21, 2019. A mentor of ARI Director Geoff Richards, Perren was a strong advocate for the freedom to explore in research in order to discover true novelties that could be developed and translated.
AO Research Institute Davos: research with impact
ARI is recognized as a research leader in Switzerland, Europe, and the world. ARI's purpose is advancing patient care through innovative orthopedic research and development. Explore a selection of ARI's notable research published in 2020.
Smart implants in fracture care—only buzzword or real opportunity?
Injury. 2020;epub Sep 17.
Ernst M, Richards RG, Windolf M.
Bacteriophage therapy as a treatment strategy for orthopaedic-device-related infections: where do we stand?
Eur Cell Mater. 2020 May 5;39:193-210.
Onsea J, Wagemans J, Pirnay JP, Di Luca M,
Gonzalez-Moreno M, Lavigne R, Trampuz A,
Moriarty TF, Metsemakers WJ.
Biphasic Plating - In vivo study of a novel fixation concept to enhance mechanobiological fracture healing
Injury. 2020 Aug;51(8):1751–1758.
Hofmann-Fliri L, Epari DR, Schwyn R, Zeiter S, Windolf M.
A Drug Holiday Reduces the Frequency and Severity of Medication-Related Osteonecrosis of the Jaw in a Minipig Model
J Bone Miner Res. 2020 Nov;35(11):2179–2192.
Otto S, Pautke C, Arens D, Poxleitner P, Eberli E, Nehrbass D, Zeiter S, Stoddart M.
Sound-induced morphogenesis of multicellular systems for rapid orchestration of vascular networks
Biofabrication. 2020;epub Sep 25.
Petta D, Basoli V, Pellicciotta D, Tognato R, Barcik
JP, Arrigoni C, Della Bella E, Armiento AR,
Candrian C, Richards GR, Alini M, Moretti M, Eglin D, Serra T.
Orbital floor repair using patient specific osteoinductive implant made by stereolithography
Biomaterials. 2020 Mar;233:119721.
Guillaume O, Geven MA, Varjas V, Varga P,
Gehweiler D, Stadelmann VA, Smidt T, Zeiter S,
Sprecher C, Bos RRM, Grijpma DW, Alini M, Yuan
H, Richards GR, Tang T, Qin L, Yuxiao L, Jiang P, Eglin D.
Computational optimisation of screw orientations for improved locking plate fixation of proximal humerus fractures
J OrthTrans. 2020 Nov;25, 96–104.
Mischler D, Markus Windolf M, Gueorguiev B, Nijs S, Varga P.
Transdermal Fentanyl Uptake at Two Different Patch Locations in Swiss White Alpine Sheep
Animals (Basel). 2020 Sep 17;10(9):1675.
Buchholz T, Hildebrand M, Heider A, Stenger V,
Arens D, Spadavecchia C, Zeiter S.
AO Trauma: Leading the way in research
Learn more about the latest research from AO Trauma in 2020 and find out more about what AO Trauma research opportunities could offer you.

Promoting excellence and shaping the future of patient care
The AO Trauma Clinical Priority Program (CPP) Bone Infection is shaping the future of patient care and inspiring a new generation of researchers.
Improving clinical outcome measurements of fracture treatment
The six-project AO Trauma Clinical Priority Program (CPP) Patient Outcome brings together orthopedic surgeons and scientists to produce a comprehensive body of patient outcome research.
AO POSSI multicenter intervention trial focuses on prevention
Prevention of infection is the most humane and cost-effective intervention and this study evaluates the effectiveness of the AO Trauma surgical site infection prevention bundle (AO POSSI).
Leveraging technology to bring scientists together
While the pandemic slowed many research activities around the world due to physicians’ increased focus on COVID-19 patients in 2020, obstacles to recruiting patients for clinical studies, and the scarcity of face-to-face meetings due to travel restrictions, AO Trauma leveraged technology to conduct the Ninth Annual Meeting of AO Trauma Clinical Priority Program (CPP) Bone Infection entirely online on September 17, 2020. Under the leadership of Prof Steven Kates, MD (principal investigator, Richmond, Virginia, United States) and Prof Edward Schwarz, PhD (coprincipal investigator, Rochester, New York, United States), CPP project leaders presented the latest updates.
Kates reported that the CPP has produced a large number of publications and attracted extramural follow-on funding, and he presented his new study on the prevention of surgical site infection after trauma (AO POSSI). Participants also heard from several other scientists—including researchers from the AO Research Institute Davos (ARI)—about their research on topics relevant to the CPP.
Research milestones from AO Spine
Learn more about the latest research from AO Spine in 2020 and its comprehensive approach involving surgeons, health care professionals, and patients.
Assessing COVID-19’s impact on health care professionals
As COVID-19 gripped the world in 2020, AO Spine surveyed over 900 spine surgeons worldwide to assess the impact of the virus on spine care professionals as well as variations that may exist geographically. The World Health Organization has requested outcomes of the study for future planning.
Learn more
Telemedicine: evaluating spine surgeons’ perspectives, practices
With telemedicine adoption accelerating worldwide in 2020, AO Spine’s global online survey of nearly 500 spine surgeons spotlighted the value of an international spine organization in describing and responding to changes in practice patterns and how we might establish “best practices” as a field moving forward.
The cutting edge: artificial intelligence and machine learning
Spine surgeons and researchers in 2020 took part in the first-ever AO Spine event focusing exclusively on spine applications for artificial intelligence and machine learning. The webinar showcased AO Spine’s dedication to harnessing the power of big data in spine surgery.
Learn more
AO Spine publishes first-ever spinal-trauma-specific outcome tool
The AO Spine Knowledge Forum Trauma in 2020 published the first universal outcome instrument specifically for spinal trauma patients. The AO Spine patient-reported spine trauma outcome measure (PROST) allows measuring and comparing different treatment options and is already available in English, Dutch, Slovak, Portuguese, German, French, Nepalese, and Arabic.
Learn more
The latest research in craniomaxillofacial surgery
Learn more about the latest research for AO CMF in 2020 and how AO CMF is at the forefront of personalization and innovation in its field.
MRONJ: evaluating treatment patterns of patients and their outcomes
This international, multicenter, prospective registry is collecting the treatment pattern data of approximately 500 patients with medication-related osteonecrosis of the jaw (MRONJ).
OFx fracture registry: documenting current practice patterns
This international, multicenter, prospective registry addresses the prevailing lack of true consensus and guidelines on the treatment of orbital fractures (OFx).
TMJ study: evaluating a treatment of last resort
This 200-patient, international, multicenter, prospective registry is collecting data on patients treated with alloplastic temporomandibular joint (TMJ) replacement, a relatively rare procedure.
BCFx: looking at bilateral condylar fractures of the mandible
Prospective data on fracture and treatment details, functional and patient-reported outcomes, and complications is being collected in approximately 250 patients with bilateral condylar fractures (BCFx) of the mandible.
MFx60: mandibular fractures registry continues
This international, multicenter, prospective registry is collecting data in around 200 patients over the age of 60 suffering from mandibular fracture (MFx60).
DMFx: investigating double mandibular fractures
This recently completed multicenter, randomized, controlled clinical investigation collected data from patients suffering from bilateral (double) mandibular fracture (DMFx).
Learn more about all the above AO CMF clinical studies here.
AO VET research in 2020
Learn more about the 2020 research activities of AO VET, a key driver of cross-pollination in the AO by leveraging innovation from human implants to improve patient care in veterinary surgery.
AO Global Data
AO VET in 2020 underscored its support for AO Global Data—the world’s most prestigious musculoskeletal data repository, with an abstract and a systematic review examining the available patient-reported outcome measures (PROMs) in small animal orthopedics.
Advancing canine orthopedics
Additionally, AO VET provided funding to the AO Innovation Translation Center (AO ITC) to support development of PROMS for fracture repair in dogs, cats, and horses, and conducted a survey advancing canine orthopedics.
AO VET Seed Fund Awards support research
True to its legacy of advancing veterinary surgery to improve patient outcomes, AO VET launched its new, 12-month AO VET Seed Fund Awards to support members pursuing research in musculoskeletal science.
AO VET symposium bridges the gap
The AO VET Symposium—Bridging the Gap: Translating Clinical Research to Clinical Practice offered researchers the chance to present their clinical research to a wide audience.
Also in 2020, AO VET advanced the Fracture Research Animal Models Database (FRAMD), awarding AO VET Research and Development funding to support final-stage rollout.
Publications
The Clinical Science unit provides medical and scientific support for internal and external clients and delivers scientifically sound clinical evidence to serve the medical community. Peer-reviewed publications in 2020 according to ePub date are:
Ongoing studies
With a team of clinical research operation specialists, the Clinical Operations unit conducts clinical studies according to the current regulatory and ethics standards. In 2020, the Clinical Operations team was running about 80 studies in 40 countries.
"In research, questioning generally accepted theorems allows and unleashes creativity."
Stephan M Perren (October 7, 1932—November 21, 2019), Director, AO Research Institute Davos (ARI), 1967-1996